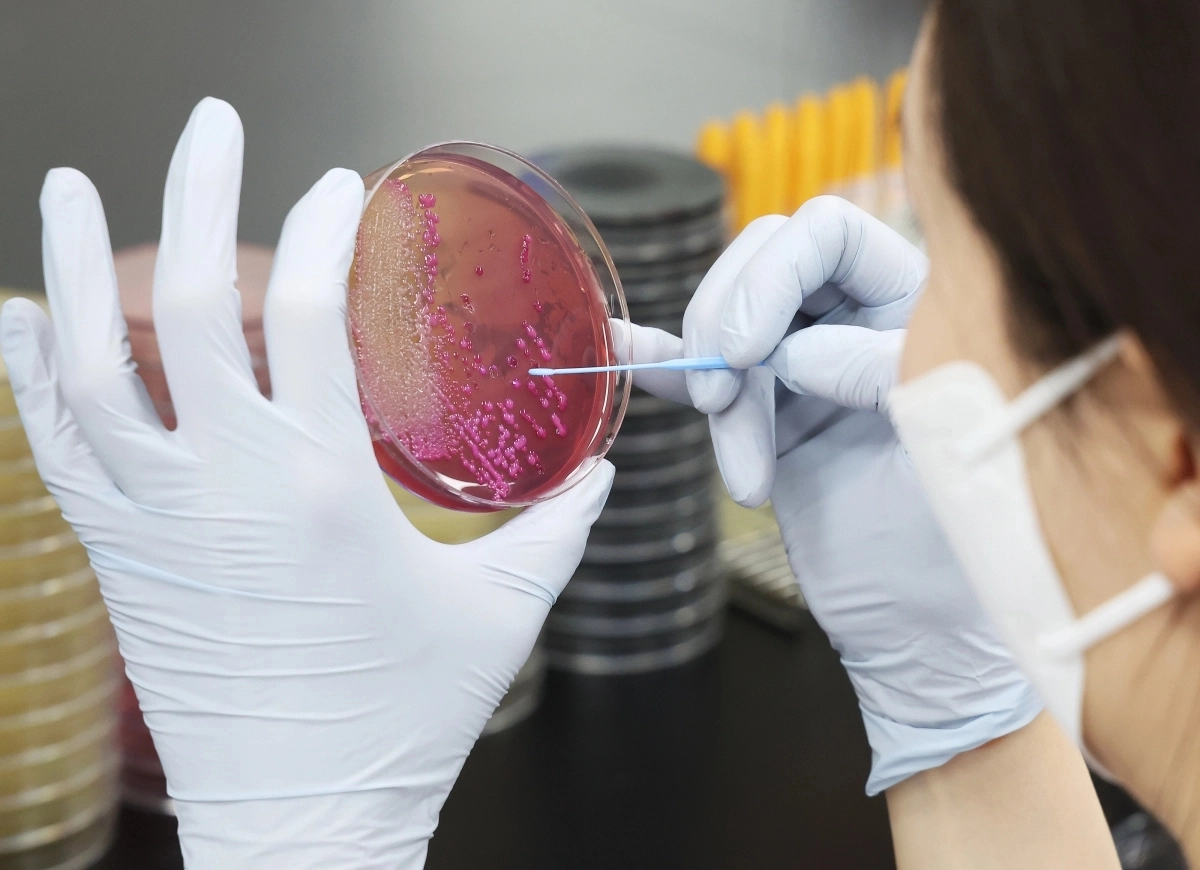

“50명이 구토·설사” 부산 중학교서 학생·교직원 집단 식중독 증세
윤예림 기자
입력 2026 03 05 14:39
수정 2026 03 05 15:27
부산의 한 중학교에서 학생과 교직원들이 집단으로 식중독 의심 증세를 보여 지자체가 역학조사에 나섰다.
5일 부산시에 따르면 지난 3일 오후 4시 40분쯤 부산 남구 한 중학교에서 학생과 교직원 등 50여명이 구토와 설사 증세를 호소한다는 신고가 접수됐다.
이 학교에서는 급식실 공사로 당일 도시락으로 점심을 먹은 것으로 알려졌다. 중환자나 입원 환자는 없는 것으로 전해졌다.
남구는 해당 음식을 수거해 부산시 보건환경연구원에 검사를 의뢰하고, 해당 업체를 상대로는 위생 점검을 진행했다. 정확한 원인 분석을 위해 학생들의 인체 검체도 진행했다.
부산시 감염병관리과 관계자는 “역학조사를 진행하고 있으며 결과가 나와야 원인을 알 수 있다”며 “증상이 심각한 학생이나 교직원은 없으며 매일 학생들의 상황을 확인하고 있다”고 말했다.
윤예림 기자
ⓒ 트윅, 무단 전재 및 재배포 금지
Q.
기사를 끝까지 읽으셨나요? 이제 AI 퀴즈로 기사의 핵심을 점검해보세요.
이 학교에서 도시락을 먹게 된 이유는?













































